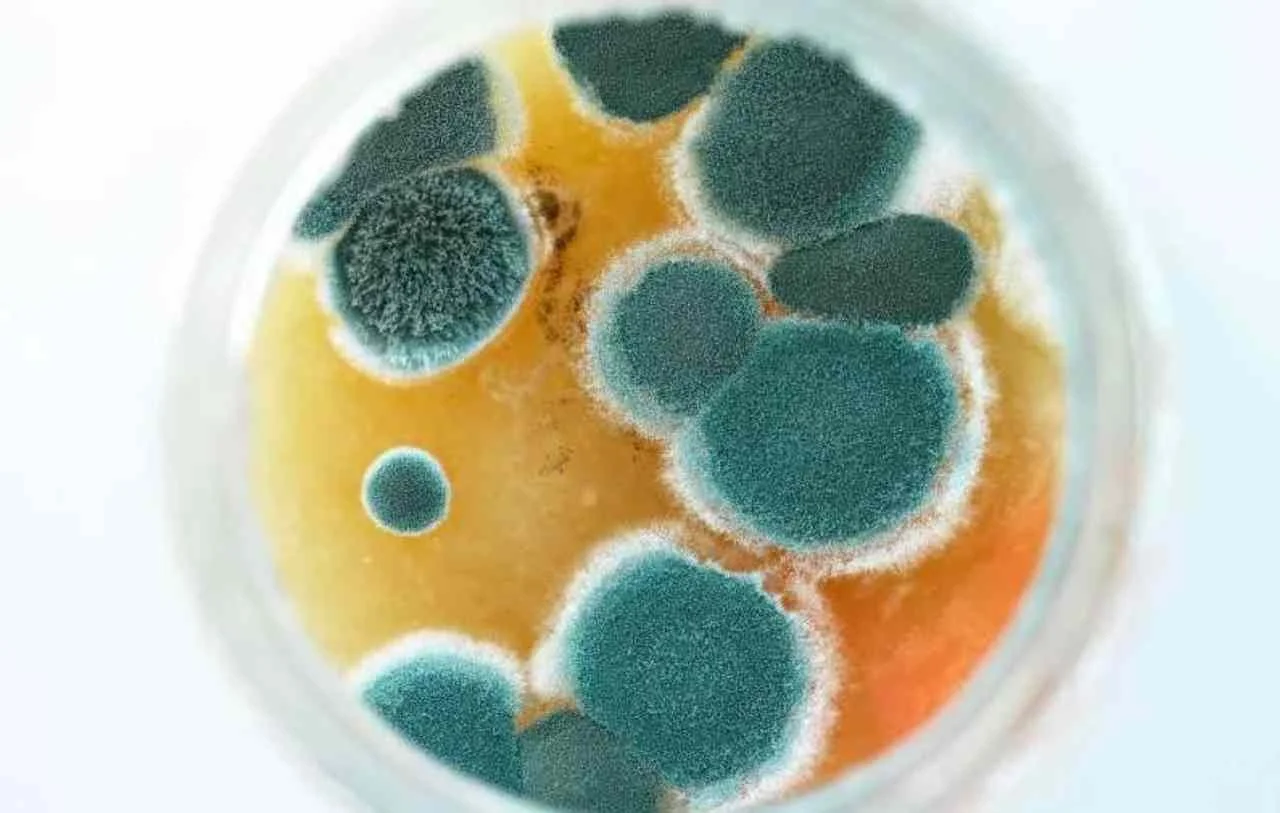
gesundheit-schimmel-wohnung

Gesundheit
Lüftungsanlagen schützen nicht nur die Bausubstanz Ihres Gebäudes, sondern auch Ihre Gesundheit. Wussten Sie, dass Europäer bis zu 90% am Tag in geschlossenen Innenräumen verbringen? Die dort auftretenden Schadstoffe sind hier bis zu 5x höher, als im Freien. Diese treten durch kontinuierliche Ausdünstungen aus Textilien, Mobiliar oder Baustoffen auf und werden von den Bewohnern eingeatmet. Wir möchten Ihnen in unseren Artikeln, den aktuellen fundierten Wissensstand zu den einzelnen Themen mitteilen.
Wählen Sie Ihr Thema.
Luftfeuchtigkeit im Haus
Schimmel in der Wohnung
Schimmel im Schlafzimmer
Radon - Risiko aus dem Boden
Feuchteschäden in Wohngebäuden
Kohlenstoffdioxid in der Luft
Luftfeuchtigkeit in der Wohnung
Luftreinigung
Bedeutung Luftqualität
Wir unterstützen Sie bei der Wahl des richtigen Lüftungssystems
Dabei prüfen wir auch verfügbare Geräte anderer Hersteller und entwickeln für Sie eine individuelle Planungslösung mit einem geeigneten Lüftungsgerät. Beantworten Sie einige Fragen zu Ihrem Objekt, damit wir Ihnen eine individuelle Lüftungslösung entwickeln können.
Jetzt Lüftungslösung anfragen

Google
5 von 5Trusted Shops
4.2 von 5Idealo
5 von 5Kununu
4.9 von 5Proven Expert
4.73 von 5